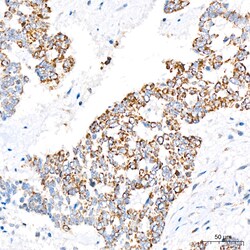
Invitrogen LRP130 Recombinant Rabbit Monoclonal Antibody (2V9I0):Antibodies:Primary

Learn More
Invitrogen™ LRP130 Recombinant Rabbit Monoclonal Antibody (2V9I0)


Rabbit Recombinant Monoclonal Antibody
£147.00 - £363.00
Specifications
| Antigen | LRP130 |
|---|---|
| Clone | 2V9I0 |
| Concentration | 0.58 mg/mL |
| Content And Storage | -20°C, Avoid Freeze/Thaw Cycles |
| Applications | ELISA, Immunohistochemistry (Paraffin), Western Blot, Immunocytochemistry |
| Product Code | Brand | Quantity | Price | Quantity & Availability | |||||
|---|---|---|---|---|---|---|---|---|---|
| Product Code | Brand | Quantity | Price | Quantity & Availability | |||||
|
30283096
|
Invitrogen™
MA557957 |
20 μL |
£147.00
20µL |
Please sign in to purchase this item. Need a web account? Register with us today! | |||||
30283395
 |
Invitrogen™
MA557958 |
100 μL |
£363.00
100µL |
Please sign in to purchase this item. Need a web account? Register with us today! | |||||
Description
Immunogen sequence: LWYEDEKHSL NSSSASTTEP DFQKDILIAC RLNQKKGAYD IFLNAKEQNI VFNAETYSNL IKLLMSEDYF TQAMEVKAFA ETHIKGFTLN DAANSRLIIT QVRRDYLKEA VTTLKTVLDQ QQTPSRLAVT RVIQALAMKG DVENIEVVQK MLNGLEDSIG LSKMVFINNI ALAQIKNNNI DAAIENIENM LTSENKVIEP QYFGLAYLFR KVIEEQLEPA VEKISIMAER LANQFAIYKP VTDFFLQLVD AGKVDDARAL LQRCGAIAEQ TPILLLFLLR NSRKQGKAST VKSVLELIPE LNEKEEAYNS LMKSYVSEKD VTSAKALYEH LTAKNTKLDD LFLKRYASLL KYAGEPVPFI EPPESFEFYA QQLRKLRENS S.
This gene encodes a deadenylase that functions as the catalytic subunit of the polyadenylate binding protein dependent poly(A) nuclease complex. The encoded protein is a magnesium dependent 3' to 5' exoribonuclease that is involved in the degradation of cytoplasmic mRNAs. Alternate splicing results in multiple transcript variants.Specifications
| LRP130 | |
| 0.58 mg/mL | |
| ELISA, Immunohistochemistry (Paraffin), Western Blot, Immunocytochemistry | |
| Unconjugated | |
| Rabbit | |
| RUO | |
| PBS with 0.05% BSA, 50% glycerol and 0.05% ProClin 300; pH 7.3 | |
| P42704 | |
| 10128 | |
| Recombinant fusion protein containing a sequence corresponding to amino acids 1014-1394 of human LRPPRC (NP_573566.2). | |
| Antibody |
| 2V9I0 | |
| -20°C, Avoid Freeze/Thaw Cycles | |
| Recombinant Monoclonal | |
| Liquid | |
| IgG | |
| Human | |
| LRPPRC | |
| 130 kDa leucine-rich protein; 3110001K13Rik; C76645; CLONE-23970; GP130; leucine rich pentatricopeptide repeat containing; leucine rich protein 157; leucine rich protein LRP130; leucine-rich pentatricopeptide repeat containing; leucine-rich PPR motif-containing protein, mitochondrial; leucine-rich PPR-motif containing; leucine-rich protein 157; LRP 130; LRP130; Lrp157; Lrpprc; LSFC; mitochondrial leucine-rich PPR motif-containing protein; rLRP157 | |
| LRPPRC | |
| Primary | |
| Protein A |
Your input is important to us. Please complete this form to provide feedback related to the content on this product.